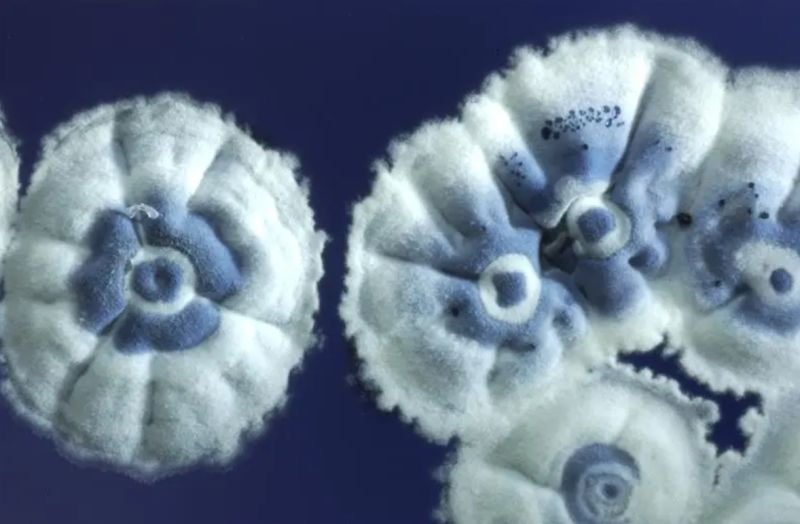
maneeshpaul's tweet image. Innovation in science may lead to happy accidents often, but it&apos;s more than just luck. As Louis Pasteur said, &quot;Chance favors only the prepared mind.&quot; A recent study on antibiotics is a perfect example.

Researchers weren&apos;t trying to find a new super-antibiotic. They were just…

Maneesh Paul
@maneeshpaul
Lead Co-inventor of #Enmetazobactam. Johns Hopkins, USFDA, MAHE, Umea, NIH trained. Techno-commercial Scientific Advisor in Planetary+One health, Microbio, #AMR
You might like
Scrolling through symptoms isn’t the same as a real diagnosis. Antimicrobials are powerful, special-use medicines. They’re not meant for trial-and-error, home guesses, or “just in case” situations. When we take them without proper diagnosis, we don’t just risk side effects, we…

Antimicrobial Resistance (AMR) didn’t suddenly appear out of nowhere, but we’ve definitely pushed it into fast-forward. Microbes have always had this natural survival trick: they learn and adapt. That part isn’t new at all. What is new? How quickly they’re learning now, because…

Want to Be a Superhero? You Actually Can. The kind who protects entire communities just by making smarter everyday choices. Antimicrobial resistance (AMR) isn’t a distant threat anymore. It’s here, it’s real, and it needs all of us to step up. And guess what? The superpowers we…
Antimicrobial resistance (AMR) doesn’t just make infections harder to treat, it quietly drains our healthcare system and our wallets. When microbes stop responding to medicines, everything becomes more expensive: longer hospital stays, stronger drugs, extra tests, and days or…




How Is AMR Draining Our Healthcare System? Antimicrobial Resistance isn’t just a medical crisis, it’s an economic one accelerating quietly in the background. When infections become harder to treat, the costs rise sharply: 🔹 Longer hospital stays and prolonged treatments 🔹…




“It’s not the medicines that change, it’s the microbes that evolve." That’s the real story behind antimicrobial resistance. I have often come across people who think antibiotics or antifungals “stop working”… but the truth is, they stay exactly the same. It’s the microorganisms…

I had the privilege of speaking at the MicroDAO’s WAAW 2025 livestream, “The Silent Pandemic: Why the World Isn’t Paying Attention (Yet).” As part of World Antimicrobial Resistance Awareness Week, this session brought together a global panel of scientists and innovators…

I was pleased to be a panellist at the One Health session at the Bengaluru Tech Summit 2025 on 20th November. The discussion reinforced a key message: Human health, animal health, and environmental systems are tightly connected and addressing them separately simply doesn’t work…



Want to Be a Superhero? You Actually Can. The kind who protects entire communities just by making smarter everyday choices. Antimicrobial resistance (AMR) isn’t a distant threat anymore. It’s here, it’s real, and it needs all of us to step up. And guess what? The superpowers we…
MicroDAO AMR Awareness Livestream #WAAW This Saturday, Nov 21st 2025; 10:00 C.E.T Join researchers, clinicians & the Web3 community as we discuss AMR and the tools @join_microdao is building to fight it @descinews 🔗 Register: luma.com/nlwcntc5

Ever thought Antimicrobial resistance (AMR) is only a “serious problem for serious infections”? Not really! Even the everyday stuff, Urinary Track Infections, ear infections, skin infections, sinus issues, a scraped knee, becomes a whole lot harder to treat when antibiotics…

Antimicrobial Resistance isn’t just a medical challenge, it’s an economic shockwave that quietly drains families, workplaces, and national health budgets. When infections no longer respond to treatment, the consequences ripple far beyond the hospital: Longer hospital stays mean…

It’s officially World Antimicrobial Awareness Week (WAAW)! 🚨 The clock is ticking on the effectiveness of our most critical medicines. Your mission for this week: 🔹 Learn: Understand that antibiotics treat bacteria, not viruses. 🔹 Act: Only take antimicrobials when…

I had the opportunity to participate in the Wadhwani Research Centre for Bioengineering (WRCB) IIT Bombay Roundtable on AMR, held at the @pic_wrcb, IIT Bombay, on 14 November 2025. As part of Roundtable, “Frontlines: Multi-Stakeholder Insights on AMR,” moderated by Dr. Savita…

Innovation in science may lead to happy accidents often, but it's more than just luck. As Louis Pasteur said, "Chance favors only the prepared mind." A recent study on antibiotics is a perfect example. Researchers weren't trying to find a new super-antibiotic. They were just…
It was an absolute pleasure to co-chair the session “Diverse Dimensions of AMR” alongside Dr. @christina_cuomo at the @ASMicrobiology–@iiscbangalore Symposium on One Health Approach to Antimicrobial Resistance (October 29-31), held at IISc Bengaluru, today. The speakers…


I’m delighted to share that I’ll be joining EcoBridge 2025 – The Indo-Israel Hackathon Finale Pitch Day at the Bangalore Bioinnovation Centre on October 27, 2025. I’ll be speaking on the Challenges of AMR in Agriculture & Food sectors - a topic that sits at the intersection of…

A recent systematic review underscores the mounting economic burden of antimicrobial resistance (AMR). The study reveals that while evidence from high-income countries dominates, major data gaps persist in low- and middle-income regions, limiting global policy action. The table…

A new study, analysis shows that the “weapons” bacteria use against rivals, called bacteriocins, are tightly tied to both virulence and antimicrobial resistance (AMR). Scanning 2,601 𝘌. 𝘤𝘰𝘭𝘪 genomes, the authors found bacteriocins in about 1 in 4 strains, carried ~3× more…
United States Trends
- 1. Happy Thanksgiving Eve 1,021 posts
- 2. Good Wednesday 20.5K posts
- 3. Luka 65K posts
- 4. Clippers 18.8K posts
- 5. #DWTS 97K posts
- 6. Lakers 50.7K posts
- 7. Robert 141K posts
- 8. Kris Dunn 2,830 posts
- 9. Collar 46.6K posts
- 10. #LakeShow 3,585 posts
- 11. Kawhi 6,506 posts
- 12. Reaves 13.3K posts
- 13. Jim Mora N/A
- 14. Karoline Leavitt 25.5K posts
- 15. Ty Lue 1,651 posts
- 16. Alix 15.3K posts
- 17. Jaxson Hayes 2,593 posts
- 18. Colorado State 2,586 posts
- 19. TOP CALL 14.8K posts
- 20. ELAINE 46.6K posts
Something went wrong.
Something went wrong.









































































































